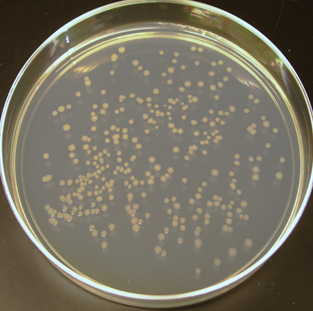

Федеральное Государственное Бюджетное Учреждение «Федеральный центр оценки безопасности и качества продукции агропромышленного комплекса»
Федеральное Государственное Бюджетное Учреждение «Федеральный центр оценки безопасности и качества продукции агропромышленного комплекса»










Обнаружено превышение КМАФАнМ
 Специалистами отдела микробиологии испытательной лаборатории ФГБУ «Оренбургский референтный центр Россельхознадзора» при проведении исследования молоко сырье в рамках лабораторного мониторинга, было обнаружено превышение КМАФАнМ. В составе КМАФАнМ представлены различные таксономические группы микроорганизмов – бактерии, дрожжи, плесневые грибы. Их общая численность свидетельствуют о санитарно-гигиеническом состоянии продукта, степени его обсемененности микрофлорой. Оптимальная температура для роста 35-37оС (в аэробных условиях); температурная граница их роста - пределах 20- 45оС. Мезофильные микроорганизмы распространены повсеместно. Повышенное количество микроорганизмов чаще всего свидетельствует о нарушениях правил и технологических режимов изготовления, сроков и температурных режимов хранения, транспортирования и реализации
Специалистами отдела микробиологии испытательной лаборатории ФГБУ «Оренбургский референтный центр Россельхознадзора» при проведении исследования молоко сырье в рамках лабораторного мониторинга, было обнаружено превышение КМАФАнМ. В составе КМАФАнМ представлены различные таксономические группы микроорганизмов – бактерии, дрожжи, плесневые грибы. Их общая численность свидетельствуют о санитарно-гигиеническом состоянии продукта, степени его обсемененности микрофлорой. Оптимальная температура для роста 35-37оС (в аэробных условиях); температурная граница их роста - пределах 20- 45оС. Мезофильные микроорганизмы распространены повсеместно. Повышенное количество микроорганизмов чаще всего свидетельствует о нарушениях правил и технологических режимов изготовления, сроков и температурных режимов хранения, транспортирования и реализации